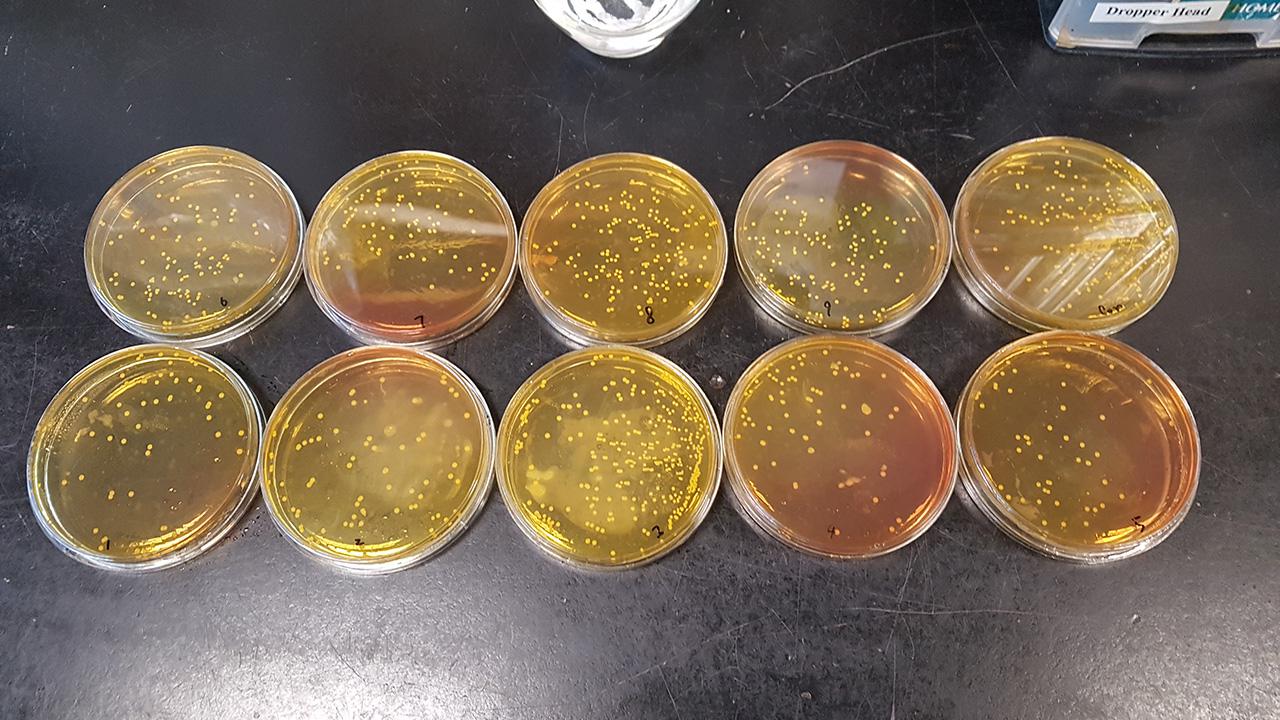

Development of Visible Light Anti-bacteria and Anti-odour Coating Materials for Vehicle Interiors
This is a visible light-triggered phtocatalytic antimicrobial coating. The coating can be applied on different surfaces by fine-tunning the chemical composition of photocatalytic antimicrobial material and mixing with silicon based sol-gel solution. The chemical properties of sol-gel solution can help to solve the adhesion problem of vehicle interiors with different surfaces.
Vehicle interiors does not get cleaned frequently, which will serve as bacteria carriers where bacteria are trapped inside the enclosed environment. The coating can equip the vehicle interiors with “self-disinfection” function by simply spraying on the surfaces. The developed coating can effectively prohibit the growth of bacteria and virus in both indoor and outdoor areas with non-UV light, and even under low light intensity of 5W.
- Antimicrobial effect takes places under visible light with low light intensity (around 5W)
- Water, alcohol, detergent-proof for on different surfaces
- Enable antimicrobial effect for different indoor venues, including public transport, hospital and toilet. Reduce manpower for indoor cleaning and maintain hygiene in indoor environment in the long run
- Reduce the risk of viral transmission
- Eco-friedly and safe, without the discharge of volatile organic compound (VOC), hazardous materials, solid or liquid waste
- All vehicle interiors
- Aeroplane cabin
- All indoor venues
Patent
- Hong Kong Short Term Patent
- China Invention Patent (Filed)
Centre of Advanced Power and Autonomous Systems (APAS) (formerly Automotive Platforms and Application Systems R&D Centre) was established in 2006 and is fully integrated as a business division under HKPC on 1 April 2025. APAS continues to undertake market-led R&D programmes spanning green transportation, smart mobility, intelligent systems and emerging applications, as well as commercialises R&D results in collaboration with industry, universities and technology institutes to enhance the competitiveness of Hong Kong's automotive and other transportation sectors in new energy and smart driving.